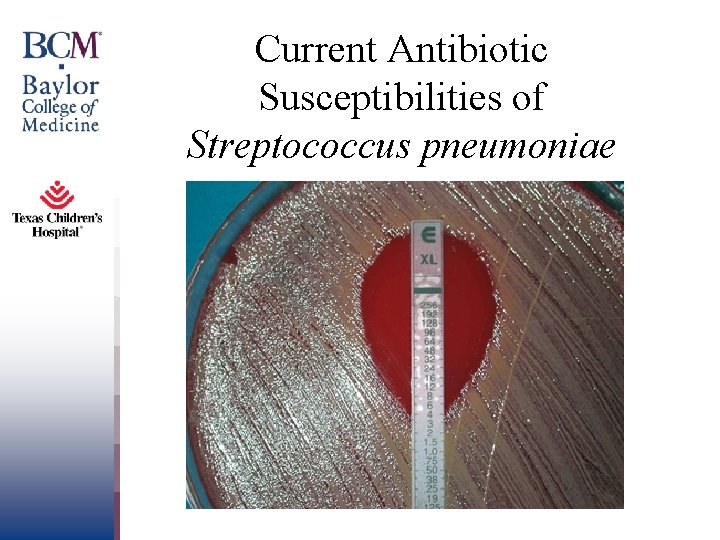
Current Antibiotic Susceptibilities of Streptococcus pneumoniae

Impact of the 13 Valent Pneumococcal Conjugate Vaccine




















































- Slides: 52

Impact of the 13 -Valent Pneumococcal Conjugate Vaccine on Pneumococcal Infections in US Children Sheldon L. Kaplan, MD Pediatrics

Disclosures • Pfizer-Grant for Investigator initiated multicenter pediatric surveillance study of invasive pneumococcal infections. • Allergan- Grant for investigator initiated study of ceftaroline in children with acute osteomyelitis • Merck-Site PI for multicenter Tedizolid study in children Pediatrics Page 2 xxx 00. #####. ppt 10/24/2020 4: 48: 42 PM

Goals • Briefly review impact of PCV 7 on invasive pneumococcal disease in US children. • Discuss the decline in IPD and local respiratory infections in US children following the introduction of PCV 13. • Note the changes in antibiotic susceptibilities of pneumococcal isolates in US children post PCV 13. • Be aware of the most common non-PCV 13 serotypes of IPD isolates post PCV 13 in the US. Pediatrics Page 3 xxx 00. #####. ppt 10/24/2020 4: 48: 42 PM

Streptococcus pneumoniae • Respiratory Infections -acute otitis media -acute mastoiditis -acute sinusitis • Invasive Infections -pneumonia -meningitis -bacteremia -septic arthritis/osteomyelitis Pediatrics Page 4 xxx 00. #####. ppt 10/24/2020 4: 48: 42 PM

Pneumococcal Conjugate Vaccine Licensed in 2000 Capsular types Saccharide size Protein carrier Conjugation method Per dose: Saccharide CRM 197 Al. PO 4 Heptavalent pneumococcal Serotypes 4, 6 B, 9 V, 14, 18 C, 19 F and 23 F All polysaccharides, except oligosaccharide of 18 C CRM 197 Reductive amination 2 µg except 6 B at 4 µg Total dose = 16 µg 20 µg 0. 5 mg

http: //www. cdc. gov/abcs/methodology/surv-pop. html Pediatrics Page 6 xxx 00. #####. ppt 10/24/2020 4: 48: 44 PM

Pediatrics Page 7 Pilishvili et al. J Infect Dis 2010; 201: 32 -41 xxx 00. #####. ppt 10/24/2020 4: 48: 44 PM

• In 2006 -7, 47% of invasive pneumococcal infections in children< 5 years old were due to serotype 19 A • The most common other serotypes were 7 F (9%), 22 F (5%), 33 F (5%), and 3 (5%). Pilishvili et al. J Infect Dis 2010; 201: 32 -41 Pediatrics Page 8 xxx 00. #####. ppt 10/24/2020 4: 48 PM

US Pediatric Multicenter Pneumococcal Surveillance Study Group Pediatrics Sheldon L. Kaplan, M. D. Edward O. Mason, Jr. , Ph. D. Kristina G. Hultén, Ph. D. Jill A. Hoffman, M. D. William J. Barson, M. D. Philana L. Lin, M. D. José R. Romero, M. D. John S. Bradley, M. D. Tina Q. Tan, M. D. Laurence B. Givner, M. D. Page 9 xxx 00. #####. ppt 10/24/2020 4: 48: 49 PM

PCV 7 Pediatrics Kaplan et al. Pediatrics 2010; 125: 429 -436 Page 10 xxx 00. #####. ppt 10/24/2020 4: 48: 52 PM

* Pediatrics Page 11 2010; 125: 429 -436 Kaplan et al. Pediatrics xxx 00. #####. ppt 10/24/2020 4: 48: 54 PM

13 -Valent Pneumococcal Conjugate Vaccine (PCV 13) • Same serotypes in PCV 7 plus 1, 3, 5, 6 A, 7 F and 19 A. • Same carrier protein as in PCV 7 -CRM 197 Pediatrics Page 12 xxx 00. #####. ppt 10/24/2020 4: 48: 55 PM

Pediatrics Page 13 MMWR March 12, 2010 xxx 00. #####. ppt 10/24/2020 4: 48: 56 PM

Direct and Indirect Impact of 13 -Valent Pneumococcal Conjugate Vaccine (PCV 13) on Invasive Pneumococcal Disease Among Children and Adults in the US Pediatrics Page 18 Pilishivili et al. 2017 IDWeek xxx 00. #####. ppt 10/24/2020 4: 49: 00 PM

Direct and Indirect Impact of 13 -Valent Pneumococcal Conjugate Vaccine (PCV 13) on Invasive Pneumococcal Disease Among Children and Adults in the US Pediatrics Page 19 Pilishivili et al. 2017 IDWeek xxx 00. #####. ppt 10/24/2020 4: 49: 01 PM

Direct and Indirect Impact of 13 -Valent Pneumococcal Conjugate Vaccine (PCV 13) on Invasive Pneumococcal Disease Among Children and Adults in the US Pediatrics Page 20 xxx 00. #####. ppt 10/24/2020 4: 49: 03 PM

Invasive Pneumococcal Disease by Year 600 500 400 US Pediatric Multicenter Pneumococcal Surveillance Group PCV 7 . PCV 13 300 200 100 0 '94'95'96'97'98'99'00'01'02'03'04'05'06'07'08'09'10 11 12 13 14 15 16 In 2015 -2016, this was 57% of the mean for 2007 -2009.

PCV 13 Serotype Distributions for Invasive Pneumococcal Infections 2007 -2016 Serotype 2007 2008 2009 2010 2011 2012 2013 2014 2015 2016 1 9 3 8 2 2 0 1 0 0 0 3 14 11 21 8 5 6 15 12 10 13 4 1 1 0 0 0 0 0 5 1 0 2 0 0 0 0 6 A 1 0 1 0 0 0 6 B 1 1 0 0 0 6 C* 6 7 9 5 5 3 5 5 6 0 7 F 15 29 29 27 11 3 2 3 1 1 9 V 1 1 0 0 0 0 14 0 1 3 0 0 0 2 18 C 0 0 3 0 0 0 1 19 A 91 82 72 61 34 16 14 8 10 6 19 F 5 3 2 2 3 1 5 3 8 10 23 F 0 1 0 0 0 1 PCV 13 PCV 7 *PCV 13 related

US Pneumococcal Multicenter Study Serotypes Causing IPD 2014 -2016 25 20 Over 2014 -2016 non PCV 13 ST isolates caused 75% of IPD 15 10 5 3 6 C 7 C 7 F 8 9 N 10 A 11 A 12 F 14 15 A 15 B 15 C 16 F 17 F 18 C 19 A 19 F 21 22 F 23 A 23 B 23 F 24 31 33 F 34 35 A 35 B 35 F 37 38 NT 0 2014 2015 2016

Most Common Underlying Conditions in Children with Invasive Pneumococcal Infections. 2007 -2009 vs. 2011 -2013 Underlying Condition Malignancies Central nervous system Genetic 2007 -2009 2011 -2013 58 (25%) 43 (27%) 27 (12%) 10 (6%) 9 (15%) 17 (11%) Cardiovascular 13 (6%) 15 (9%) HIV 1 (< 1%) 4 (3%) Hemoglobinopathy 9 (4%) 5 (3%) Renal 12 (5%) 13 (8%) Asplenia 4 (2%) 5 (3%) Other 98 (49%) 29 (55%) Total 231/626 (37%) 160/352 (45%)* Kaplan et al. 2014 IDWeek *p=0. 009

Invasive Pneumococcal Disease Location Massachusetts Pediatrics Vaccine Schedule Surveillance Type Final Year Baseline Decline PCV 7 -2000 PCV 13 -2010 (2, 4, 6, 12 -15) Statewide surveillance 2012 Pre-PCV 13 < 5 y- 50% PCV 13 ST- 50% Mainly 19 A and 7 F 1 Tam Page 25 et al. Pediatrics 2014; 134: 210 xxx 00. #####. ppt 10/24/2020 4: 49: 11 PM

Dallas Gaviria-Agudelo et al. J Pediatr Infect Dis Soc 2016 Feb 22 [Epub ahead of print] Pediatrics Page 26 xxx 00. #####. ppt 10/24/2020 4: 49: 11 PM

July 1, 2004 -June 30, 2013 Annual number of cases Pediatrics 260 135 Page 27 Moore et. al. Lancet Infect Dis 2015; 15: 301 xxx 00. #####. ppt 10/24/2020 4: 49: 14 PM 48% Decrease

Pediatrics Greenhow et al. Pediatrics 2017; 139: e 20162098 Page 28 xxx 00. #####. ppt 10/24/2020 4: 49: 16 PM

Site of Invasive Pneumococcal Infections 2007 -2016 Diagnosis 2007 2008 2009 2010 2011 2012 2013 2014 2015 2016 Bacteremia 66 80 82 58 50 44 39 64 40 52 Pneumonia 63 63 75 55 32 29 26 31 29 34 Mastoiditis 31 15 27 13 4 3 5 10 4 5 Meningitis 26 26 25 28 23 22 26 16 19 24 Abscess 8 5 5 5 8 5 5 4 8 3 Septic Arthritis 6 6 5 1 3 2 0 3 3 2 Cellulitis 3 1 4 1 2 0 4 7 6 4 Osteomyelitis 3 2 3 1 1 2 4 4 2 3 Peritonitis 3 2 2 1 3 2 2 0 0 3 Other 3 4 1 5 2 4 1 6 2 1 212 204 229 168 128 113 112 145 113 131

Pneumococccal Pneumonia and Empyema Pediatrics Page 31 xxx 00. #####. ppt 10/24/2020 4: 49: 17 PM

July 1, 2004 -June 30, 2013 Annual number of cases Pediatrics 236 110 Page 32 Moore et. al. Lancet Infect Dis 2015; 15: 301 xxx 00. #####. ppt 10/24/2020 4: 49: 18 PM 53% Decrease

Pediatrics Wiese et al. Vaccine Page 2016; 34: 6243 -6249 33 xxx 00. #####. ppt 10/24/2020 4: 49: 19 PM

Pediatrics Wiese et al. Vaccine Page 2016; 34: 6243 -6249 34 xxx 00. #####. ppt 10/24/2020 4: 49: 21 PM

Pneumococcal Pneumonia Requiring Hospitalization in U. S. Children in the 13 -Valent Pneumococcal Conjugate Vaccine Era Pediatrics Olarte et al. Clin Infect. Page Dis 2017; 64: 1699 -1704 35 xxx 00. #####. ppt 10/24/2020 4: 49: 22 PM

Pneumococcal Pneumonia Requiring Hospitalization in U. S. Children in the 13 -Valent Pneumococcal Conjugate Vaccine Era Pediatrics Olarte et al. Clin Infect. Page Dis 2017; 64: 1699 -1704 36 xxx 00. #####. ppt 10/24/2020 4: 49: 23 PM

Pneumococcal Meningitis Pediatrics Page 37 xxx 00. #####. ppt 10/24/2020 4: 49: 24 PM

July 1, 2004 –June 30, 2013 Annual number of cases Pediatrics 51 36 Page 38 Moore et. al. Lancet Infect Dis 2015; 15: 301 xxx 00. #####. ppt 10/24/2020 4: 49: 25 PM 29% Decrease

Pediatrics Olarte et al. Clin Infect. Page. Dis 39 2015; 61: 767 -775 xxx 00. #####. ppt 10/24/2020 4: 49: 25 PM

19 9 19 4 9 19 5 9 19 6 97 19 98 19 99 20 0 0 20 1 0 20 2 0 20 3 0 20 4 0 20 5 0 20 6 0 20 7 0 20 8 09 20 10 20 1 1 20 2 1 20 3 1 20 4 1 20 5 16 US Pediatric Multicenter Pneumococcal Surveillance Group Pneumococcal Meningitis 70 60 50 40 30 20 10 0

Children < 2 y decreased 2. 2 to 1. 2 (P=0. 1) P<0. 01 No change in mortality rate Pediatrics Jacobs et al. Vaccine Page 2017; 35: 6160 -6165 41 xxx 00. #####. ppt 10/24/2020 4: 49: 27 PM

Streptococcus pneumoniae Upper Respiratory Infections Acute otitis media Pediatrics Mastoiditis Page 42 xxx 00. #####. ppt 10/24/2020 4: 49: 29 PM

Pediatrics 43 Zhou et al. Pediatrics. Page 2008; 121: 253 -260 xxx 00. #####. ppt 10/24/2020 4: 49: 31 PM

Pediatrics Page 44 Marom et. al. JAMA Pediatr 2014; 168: 168 -1751 xxx 00. #####. ppt 10/24/2020 4: 49: 31 PM

Pediatrics Page 45 Kaplan et al. Clin Infect Dis 2015; 60: 1335 -1345 xxx 00. #####. ppt 10/24/2020 4: 49: 34 PM

Pediatrics Page 46 Kaur et al. Pediatrics 2017; 140: e 20170181 xxx 00. #####. ppt 10/24/2020 4: 49: 35 PM

Pediatrics Howitz et al. Vaccine 2017; 35: 5858 -5863 Page 47 xxx 00. #####. ppt 10/24/2020 4: 49: 38 PM

Sinusitis Pediatrics Page 48 Up. To. Date® xxx 00. #####. ppt 10/24/2020 4: 49: 40 PM

Pediatrics Page Dis 49 Olarte et al. Pediatr Infect J 2014; 33: 1033 -1036 xxx 00. #####. ppt 10/24/2020 4: 49: 41 PM

Pediatrics Capra et al. JAMA Otolaryngol Head Neck Surg 2015; 12 -17 Page 50 xxx 00. #####. ppt 10/24/2020 4: 49: 43 PM

Pediatrics Marom et a. Pediatr Infect Page 51 Dis J 2017; 36: 314 -318 xxx 00. #####. ppt 10/24/2020 4: 49: 44 PM
Current Antibiotic Susceptibilities of Streptococcus pneumoniae

Over 95% with MIC < 2 µg/ml

only 5 isolates (~1%) had ceftriaxone MICs > 1 µg/ml

Impact of PCV 13 on Antibiotic Susceptibilities of Streptococcus pneumoniae Isolates from IPD • CDC-Reductions of 78 -96% for IPD by isolates non-susceptible to penicillin, erythromycin, and multiply non-susceptible for children < 5 yo. 1 • Massachusetts-Increases in susceptibilities to penicillin (p=0. 054) and tetracycline (p=0. 028). 2 1 Moore Pediatrics et. al. Lancet Infect Dis 2015; 15: 301; 2 Tam et al. Pediatrics 2014; 134: 210 Page 55 xxx 00. #####. ppt 10/24/2020 4: 49: 48 PM

Conclusions • Invasive pneumococcal infections in children have been reduced substantially in the US following the introduction of PCV 7 and PCV 13. • Majority of IPD cases in children < 5 years old the US are now are due non PCV 13 serotypes. • Upper respiratory infections including complications of infections related to S. pneumoniae have decreased following PCV 13 use. • Antibiotic susceptibility rates have increased among pneumococcal isolates following PCV 13 implementation. Pediatrics Page 56 xxx 00. #####. ppt 10/24/2020 4: 49: 48 PM

Thank You Pediatrics Page 57 xxx 00. #####. ppt 10/24/2020 4: 49: 48 PM